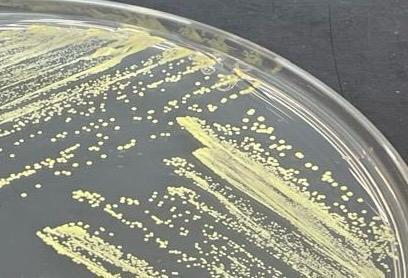

Türk bilim insanları 'en büyük keşif' diyerek dünyaya duyurdu: Yeni bir cins
15.02.2025 - 11:36 | Son Güncellenme:
AA
İstanbul Üniversitesi'nden (İÜ) bilim insanları, uçak yakıtlarından alınan örneklerde yapılan araştırmalar sonucunda "Facivitalis İstanbulensis" adlı yeni bir bakteri cinsi keşfetti.
İÜ Fen Fakültesi Biyoloji Bölümü Temel ve Endüstriyel Mikrobiyoloji Anabilim Dalı Öğretim Üyesi Prof. Dr. Esra Sungur ile Doç. Dr. Miray Onan ve Dr. Öğretim Üyesi Simge Arkan Özdemir tarafından 3 yıl önce başlatılan çalışma kapsamında, uçak yakıtından alınan örnekler araştırma laboratuvarında incelendi.
Yapılan araştırmalar sonucunda, çevresel koşullara son derece dayanıklı, ekstrem koşullara uyum sağlayan, "Facivitalis İstanbulensis" adlı yeni bir bakteri cinsi keşfedildi.
Keşfedilen "Facivitalis İstanbulensis" adlı bakteri, Antonie van Leeuwenhoek dergisinde yayınlanması ve validasyon onayını almasıyla bilim dünyasında tescillendi.
Yeni bakteri, çevre kirliliğini önleme ve sürdürülebilir enerji üretimi gibi kritik alanlarda kullanılacak.

"İLERİ ANALİZLER YAPTIKÇA BAKTERİNİN YENİ BİR CİNS OLDUĞUNU GÖRDÜK"
Prof. Dr. Esra Sungur, AA muhabirine, araştırmanın bir doktora öğrencisinin tez çalışması kapsamında başladığını söyledi.
Araştırmada mikroorganizmaların yol açtığı korozyonla ilgili çalışma yaptıklarını belirten Sungur, bu kapsamda özel bir uçak şirketinden uçak yakıtı temin ettiklerini anlattı.
Sungur, çalışmada ilk önce hedeflerinin "mangan okside eden" bir bakteriyi izole ederek, mikrobiyolojik korozyon deneylerini yapmak olduğunu kaydetti.
Bakteriyi izole ettiklerinde ilk başta yeni bir bakteri cinsi bulduklarının farkında olmadıklarını dile getiren Sungur, "Biz ilk izole ettiğimizde bulduğumuz bakterinin sphingomonas cinsinin yeni bir türü olduğunu düşündük açıkçası. Çalışmalar ilerledikçe, ileri analizler yaptıkça aslında bakterinin yeni bir tür olmadığını, yeni bir cins olduğunu gördük ve bir üst seviyeye daha çıkmış olduk." diye konuştu.

"ARAŞTIRMAMIZDA BAKTERİMİZİN BAZI ÖZEL GENLER TAŞIDIĞINI GÖRDÜK"
Prof. Dr. Sungur, bunun üzerine daha detaylı analizler yapmaya başladıklarını anlattı.
Yeni bakteri cins ve türlerinin dünyadaki bazı taksonomi merkezlerince kabul edilmesi gerektiğini kaydeden Sungur, bu kapsamda başvuru yaptıklarını, onayın ardından makaleyi dünya kamuoyuna duyurduklarını ifade etti.
Sungur, buldukları bakterinin izole edildiği koşullar açısından ekstrem bir koşulda olduğunu, bu koşullarda her bakterinin yaşayamayacağını belirtti.
Bu durumun, buldukları bakterinin çok farklı özelliklerinin olduğunun göstergesi olduğunu dile getiren Sungur, "Çalışmada ileri moleküler analizler yaptık ve bakterimizi tanıdık. Araştırmamızda bakterimizin bazı özel genler taşıdığını gördük. Bu genlerin, bakterinin çevresel koşullara adapte olmasını, zorlu koşullarda yaşamasını sağlayacak, virülans ve patojeniteye karşı mücadeleye katkıda bulunabilecek çok ekstrem özellikleri olduğunu gördük." şeklinde konuştu.
"AROMATİKLERİ PARÇALAMA KONUSUNDA 58 GEN İÇERDİĞİNİ TESPİT ETTİK"
Prof. Dr. Sungur, çalışmada keşfettikleri bakteri cinsinin bulunduğu ortamda nasıl yaşadığına ilişkin, şu bilgileri verdi:
"Çünkü uçak yakıtı diye düşündüğünüzde, bakteri olabilir ama o da bir canlı. Mikron seviyesinde olabilir ama her canlı gibi aslında onların da gereksinimleri var. Bizim gibi onların da en önemli gereksinimi besindir. Böyle bir besini uçak yakıtında bakteri nasıl bulabilir? sorusunu sorduğumuzda, yakıt aslında hidrokarbon içerir. O zaman bu bakterinin hidrokarbonları parçalayabilmesi gerekir diye düşündük. Bunun ardından biyoinformatik ortoloji analizlerini yaptık, bakterimizin hidrokarbonları parçalayabildiğini gördük."
Çalışmada bu işi yapan 100 tane gen olduğunu tespit ettiklerini vurgulayan Sungur, "Hidrokarbon yapısında farklı bileşenler vardır. Aromatikler, halka yapısında parçalanması çok zor bileşiklerdir. Bakterinin bu konuda çok yetenekli olduğunu gördük. Aromatikleri parçalama konusunda 58 gen içerdiğini tespit ettik. Bir diğer özelliği bakterinin biyosürfaktan üretmek için gerekli olan genleri taşıdığını gördük. Bu genlerin 9'unun sadece bizim bakterimizde bulunduğunu tespit ettik." ifadelerini kullandı.
Sungur, bu bakterinin Sphingomonadaceae ailesi içerisinde yer aldığını belirterek, şöyle devam etti:
"Bu aile içerisindeki bakteriler sıklıkla hidrokarbon biyoremediasyon çalışmalarında, yani petrolle kirlenmiş alanların temizlenmesi çalışmalarında kullanılıyor. Bizim bakterimiz de bu ailenin yeni bir üyesi oldu, biz yeni bir üye kazandırdık. Bu yeni üyemizin kendine has özel genleri var. Bu genlere sahip olan bakterimiz, biyoteknolojik çalışmaların geliştirilmesi için potansiyel yeni bir mikroorganizmadır. Bakterimiz çevre kirliliğinin giderilmesi alanında açıkçası çok yaygın yer bulacaktır."

"İNSANLAR AÇISINDAN DA ÇOK KIYMETLİ"
Prof. Dr. Sungur, bakterinin cins adının "Facivitalis", tür adının ise "İstanbulensis" olduğunu dile getirdi.
Facivitalis isminin "uçak yakıtında yaşayan" demek olduğunu anlatan Sungur, "İstanbulensis" isminin ise İstanbul Üniversitesi'ne atfettikleri için koyduklarını kaydetti.
Sungur, her mikrobiyoloğun hayalinin yeni bir cins, yeni bir tür bakteri keşfetmek olduğunu aktararak, "Doğada var olup, sizin onu bilmediğiniz, tanımadığınız, tanınmayan birini ortaya çıkarmak aslında en büyük keşiftir. Sonrasında da bu bulduğunuz keşfin eğer insanlık açısından ya da biyoteknolojik çalışma açısından kıymetli olduğunu görürseniz, o zaman yaptığınız iş anlam kazanıyor. Kimlerle beraber bu dünyayı paylaştığımızı ortaya koymak aslında sadece bilimsel açıdan değil, tüm insanlar açısından da çok kıymetli." şeklinde konuştu.